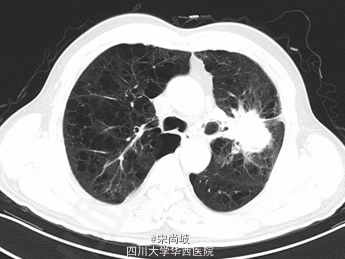

下载或打开 医联APP 查看完整评论
立即下载
打开APP
COPD可进展为肺癌?
主诉 病史
患者为老年男性,反复咳嗽咳痰40+年,加重伴咳血10天入院。患者吸烟30包年。诊断COPD10年,此次加重。

查体 辅查
胸廓桶状,双肺呼吸音过清。胸部CT提示双肺慢支炎肺气肿表现,左肺上叶见4.9*4.0CM软组织肿块。
诊断 处理
诊断为:左上肺包块。全麻下行剖胸探查+左肺上叶肿物取活检术,术中见胸内淡黄色积液50ml, 轻度粘连,胸膜有种植; 肿块位于肺门部及上下肺叶,约8*7*7cm大小,有脏层胸膜皱缩、有侵犯壁层胸膜;肿瘤距隆突<2cm,侵及纵隔胸膜,心包;淋巴结肿大及侵犯情况:7组,10组,11组淋巴结肿大,质硬,与周围组织紧密粘连;术中冰冻果:(左上肺肿物)倾向非小细胞型肺癌,术中特殊情况:左上肺肿物侵入左下肺及左肺门部,质硬,活动度差,周围淋巴结肿大,质硬,与肿物紧密粘连,无法分离。术中过程顺利,术中出血约50ml,术后安返,给予止痛,抗炎,化痰等治疗。

随访 讨论
此病例由于长期吸烟,COPD反复发作伴感染,可能由于长期炎症刺激引发肿瘤发生,这为吸烟人群敲响警钟。吸烟有害健康!
发布于 15-07-09 23:56
